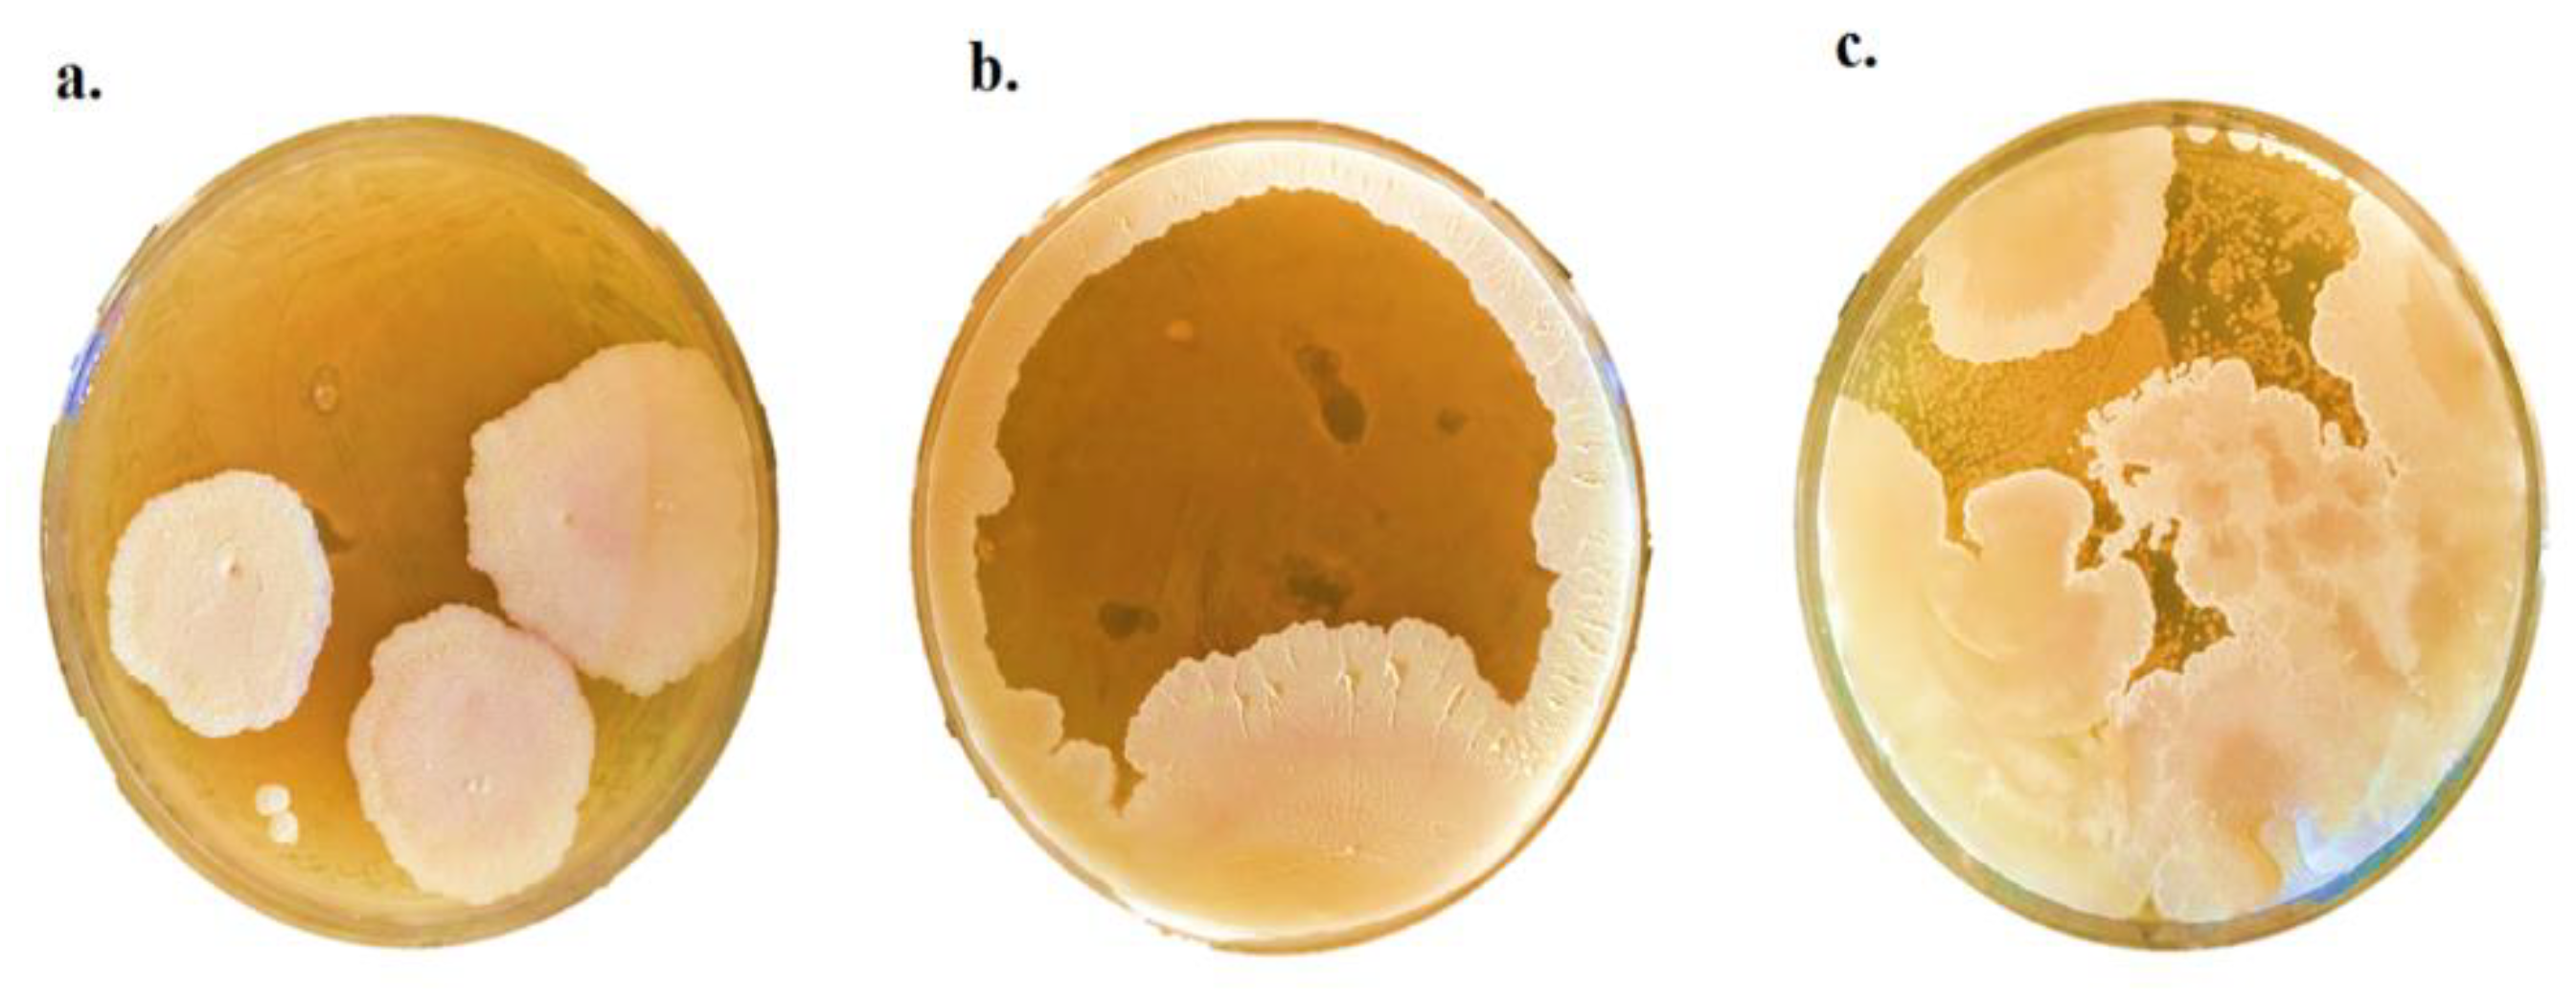
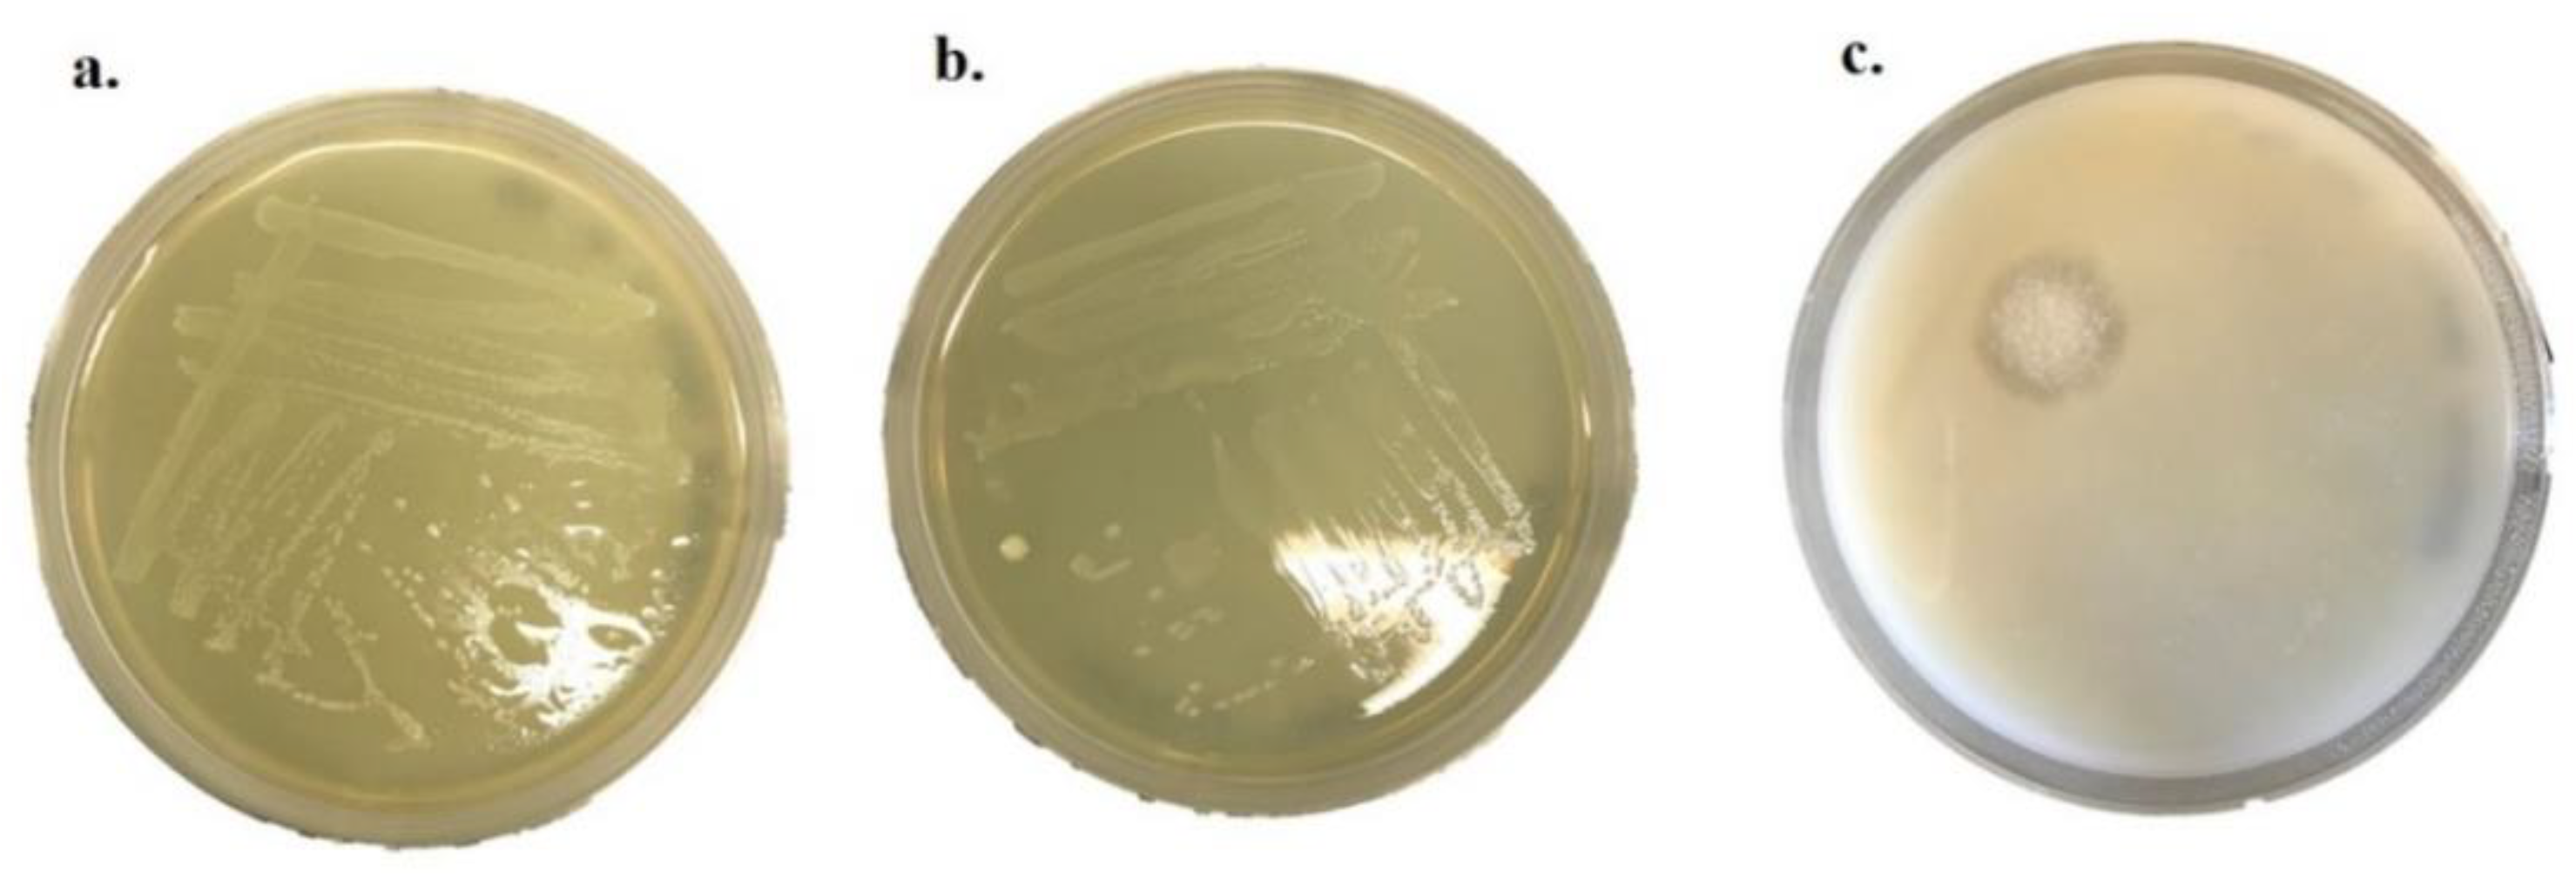

Evaluation of the Safety and Ochratoxin A Degradation Capacity of Pediococcus pentosaceus as a Dietary Probiotic with Molecular Docking Approach and Pharmacokinetic Toxicity Assessment
Abstract
:1. Introduction
2. Results
2.1. Molecular Characterization and Phylogenetic Analysis
2.2. Resistance to Different pH and Bile Salts
2.3. Antibiotic Sensitivity Test
2.4. Antifungal Activity of P. pentosaceus
2.5. Hemolytic Activity
2.6. Enzymatic Activity
2.7. Detoxification of OTA
2.8. Computational Approach to Detoxification
2.8.1. Molecular Docking Experiment
2.8.2. Computational Toxicity Assessment
ADMET Analysis
ProTox-II Server Analysis
3. Discussion
4. Materials and Methods
4.1. Sample Collection
4.2. Microbial Culture, Isolation of LAB and Molecular Identification
4.3. Fungal Cultures and Preparations
4.4. Evaluation of Probiotic Characteristics
4.4.1. pH-Resistant
4.4.2. Bile-Salt-Resistant
4.4.3. Antibiotic Susceptibility Test
4.4.4. Enzymatic Activity
4.4.5. Bile Salt Hydrolase (BSH) and Hemolytic Activity
4.5. Antifungal Property of the Isolate
4.6. OTA Analysis of Growing Bacteria Adsorption using HPLC
4.7. Molecular Docking
4.8. In Silico Toxicity Assessment
4.9. Statistical Analysis
5. Conclusions
Author Contributions
Funding
Institutional Review Board Statement
Informed Consent Statement
Data Availability Statement
Acknowledgments
Conflicts of Interest
References
- Sharma, V.; Patial, V. Food Mycotoxins: Dietary Interventions Implicated in the Prevention of Mycotoxicosis. ACS Food Sci. Technol. 2021, 1, 1717–1739. [Google Scholar] [CrossRef]
- Lozowicka, B.; Iwaniuk, P.; Konecki, R.; Kaczynski, P.; Kuldybayev, N.; Dutbayev, Y. Impact of Diversified Chemical and Biostimulator Protection on Yield, Health Status, Mycotoxin Level, and Economic Profitability in Spring Wheat (Triticum aestivum L.) Cultivation. Agronomy 2022, 12, 258. [Google Scholar] [CrossRef]
- World Health Organization. Chernobyl: The WHO Helps; No. WHO-PEP--93.4; World Health Organization: Geneva, Switzerland, 1993. [Google Scholar]
- FAO. The State of Agricultural Commodity Markets 2015–2016. Trade and Food Security: Achieving a Better Balance between National Priorities and the Collective Good; Accessed on 19 April 2018; Food and Agriculture Organization of the United Nations: Rome, Italy, 2015. [Google Scholar]
- EFSA Panel on Contaminants in the Food Chain (CONTAM); Schrenk, D.; Bodin, L.; Chipman, J.K.; del Mazo, J.; Grasl-Kraupp, B.; Hogstrand, C.; Hoogenboom, L.; Leblanc, J.C.; Nebbia, C.S.; et al. Risk assessment of ochratoxin A in food. EFSA J. 2020, 18, e06113. [Google Scholar]
- Samuel, M.S.; Jeyaram, K.; Datta, S.; Chandrasekar, N.; Balaji, R.; Selvarajan, E. Detection, Contamination, Toxicity, and Prevention Methods of Ochratoxins: An Update Review. J. Agric. Food Chem. 2021, 69, 13974–13989. [Google Scholar] [CrossRef] [PubMed]
- Kuchheuser, P.; Birringer, M. Pesticide residues in food in the European Union: Analysis of notifications in the European Rapid Alert System for Food and Feed from 2002 to 2020. Food Control 2021, 133, 108575. [Google Scholar] [CrossRef]
- Bui-Klimke, T.R.; Wu, F. Ochratoxin A and Human Health Risk: A Review of the Evidence. Crit. Rev. Food Sci. Nutr. 2013, 55, 1860–1869. [Google Scholar] [CrossRef] [PubMed]
- Belkacem-Hanfi, N.; Fhoula, I.; Semmar, N.; Guesmi, A.; Perraud-Gaime, I.; Ouzari, H.-I.; Boudabous, A.; Roussos, S. Lactic acid bacteria against post-harvest moulds and ochratoxin A isolated from stored wheat. Biol. Control 2014, 76, 52–59. [Google Scholar] [CrossRef]
- Frakolaki, G.; Giannou, V.; Kekos, D.; Tzia, C. A review of the microencapsulation techniques for the incorporation of probiotic bacteria in functional foods. Crit. Rev. Food Sci. Nutr. 2020, 61, 1515–1536. [Google Scholar] [CrossRef]
- Yadav, A.S.; Kolluri, G.; Gopi, M.; Karthik, K.; Malik, Y.S.; Dhama, K. Exploring alternatives to antibiotics as health promoting agents in poultry—A review. J. Exp. Biol. Agric. Sci. 2016, 4, 368–383. [Google Scholar] [CrossRef]
- Bangar, S.P.; Sharma, N.; Kumar, M.; Ozogul, F.; Purewal, S.S.; Trif, M. Recent developments in applications of lactic acid bacteria against mycotoxin production and fungal contamination. Food Biosci. 2021, 44, 101444. [Google Scholar] [CrossRef]
- Fair, R.J.; Tor, Y. Antibiotics and Bacterial Resistance in the 21st Century. Perspect. Med. Chem. 2014, 6, S14459. [Google Scholar] [CrossRef] [PubMed]
- Cramer, B.; Harrer, H.; Nakamura, K.; Uemura, D.; Humpf, H.-U. Total synthesis and cytotoxicity evaluation of all ochratoxin A stereoisomers. Bioorg. Med. Chem. 2010, 18, 343–347. [Google Scholar] [CrossRef] [PubMed]
- Kaur, R.; Tiwari, S.K. Isolation, identification and characterization of Pediococcuspentosaceus LB44 and Weissellaconfusa LM85 for the presence of bacteriocin-like inhibitory substances (BLIS). Microbiology 2016, 85, 540–547. [Google Scholar] [CrossRef]
- Abrunhosa, L.; Ines, A.; Rodrigues, A.I.; Guimaraes, A.; Pereira, V.L.; Parpot, P.; Mendes-Faia, A.; Venâncio, A. Biodegradation of ochratoxin A by Pediococcusparvulus isolated from Douro wines. Int. J. Food Microbiol. 2014, 188, 45–52. [Google Scholar] [CrossRef] [PubMed]
- De Bellis, P.; Tristezza, M.; Haidukowski, M.; Fanelli, F.; Sisto, A.; Mulè, G.; Grieco, F. Biodegradation of Ochratoxin A by Bacterial Strains Isolated from Vineyard Soils. Toxins 2015, 7, 5079–5093. [Google Scholar] [CrossRef] [PubMed]
- Rodriguez, H.; Reveron, I.; Doria, F.; Costantini, A.; De Las Rivas, B.; Muňoz, R.; Garcia-Moruno, E. Degradation of Ochratoxin A by Brevibacterium Species. J. Agric. Food Chem. 2011, 59, 10755–10760. [Google Scholar] [CrossRef] [PubMed]
- Ferenczi, S.; Cserhati, M.; Krifaton, C.; Szoboszlay, S.; Kukolya, J.; Szoke, Z.; Koszegi, B.; Albert, M.; Barna, T.; Mézes, M.; et al. A new ochratoxin A biodegradation strategy using Cupriavidusbasilensis Őr16 strain. PLoS ONE 2014, 9, e109817. [Google Scholar] [CrossRef] [PubMed]
- Chang, X.; Wu, Z.; Wu, S.; Dai, Y.; Sun, C. Degradation of ochratoxin A by Bacillus amyloliquefaciens ASAG1. Food Addit. Contam. Part A 2015, 32, 564–571. [Google Scholar] [CrossRef]
- Shi, L.; Liang, Z.; Li, J.; Hao, J.; Xu, Y.; Huang, K.; Tian, J.; He, X.; Xu, W. Ochratoxin A biocontrol and biodegradation by Bacillus subtilis CW 14. J. Sci. Food Agric. 2013, 94, 1879–1885. [Google Scholar] [CrossRef]
- Fhoula, I.; Najjari, A.; Turki, Y.; Jaballah, S.; Boudabous, A.; Ouzari, H. Diversity and Antimicrobial Properties of Lactic Acid Bacteria Isolated from Rhizosphere of Olive Trees and Desert Truffles of Tunisia. BioMed Res. Int. 2013, 2013, 405708. [Google Scholar] [CrossRef]
- Luz, C.; Ferrer, J.; Mañes, J.; Meca, G. Toxicity reduction of ochratoxin A by lactic acid bacteria. Food Chem. Toxicol. 2018, 112, 60–66. [Google Scholar] [CrossRef] [PubMed]
- Cruz-Guerrero, A.; Hernández-Sánchez, H.; Rodríguez-Serrano, G.; Gómez-Ruiz, L.; García-Garibay, M.; Figueroa-González, I. Commercial probiotic bacteria and prebiotic carbohydrates: A fundamental study on prebiotics uptake, antimicrobials production and inhibition of pathogens. J. Sci. Food Agr. 2014, 94, 2246–2252. [Google Scholar] [CrossRef] [PubMed]
- Papagianni, M.; Anastasiadou, S. Pediocins: The bacteriocins of Pediococci. Sources, production, properties and applications. Microb. Cell Factories 2009, 8, 3. [Google Scholar] [CrossRef]
- Taroub, B.; Salma, L.; Manel, Z.; Ouzari, H.-I.; Hamdi, Z.; Moktar, H. Isolation of lactic acid bacteria from grape fruit: Antifungal activities, probiotic properties, and in vitro detoxification of ochratoxin A. Ann. Microbiol 2019, 69, 17–27. [Google Scholar] [CrossRef]
- Del Prete, V.; Rodríguez, H.; Carrascosa, A.V.; de las Rivas, B.; Garcia-Moruno, E.; Muñoz, R. In Vitro Removal of Ochratoxin A by Wine Lactic Acid Bacteria. J. Food Prot. 2007, 70, 2155–2160. [Google Scholar] [CrossRef]
- Bornscheuer, U.T. Microbial carboxyl esterases: Classification, properties and application in biocatalysis. FEMS Microbiol. Rev. 2002, 26, 73–81. [Google Scholar] [CrossRef] [PubMed]
- Shimizu, S.; Kataoka, M.; Shimizu, K.; Hirakata, M.; Sakamoto, K.; Yamada, H. Purification and characterization of a novel lactonohydrolase, catalyzing the hydrolysis of aldonate lactones and aromatic lactones, from Fusarium oxysporum. JBIC J. Biol. Inorg. Chem. 1992, 209, 383–390. [Google Scholar] [CrossRef]
- Vanhoutte, I.; Audenaert, K.; De Gelder, L. Biodegradation of Mycotoxins: Tales from Known and Unexplored Worlds. Front. Microbiol. 2016, 7, 561. [Google Scholar] [CrossRef]
- Jin, H.; Li, B.; Peng, X.; Chen, L. Metagenomic analyses reveal phylogenetic diversity of carboxypeptidase gene sequences in activated sludge of a wastewater treatment plant in Shanghai, China. Ann. Microbiol. 2013, 64, 689–697. [Google Scholar] [CrossRef]
- Zhang, Z.-Y.; Pan, L.-P.; Li, H.-H. Isolation, identification and characterization of soil microbes which degrade phenolic allelochemicals. J. Appl. Microbiol. 2010, 108, 1839–1849. [Google Scholar] [CrossRef]
- Tamura, K.; Peterson, D.; Peterson, N.; Stecher, G.; Nei, M.; Kumar, S. MEGA5: Molecular Evolutionary Genetics Analysis Using Maximum Likelihood, Evolutionary Distance, and Maximum Parsimony Methods. Mol. Biol. Evol. 2011, 28, 2731–2739. [Google Scholar] [CrossRef] [PubMed]
- Vlková, E.; Rada, V.; Popelářová, P.; Trojanová, I.; Killer, J. Antimicrobial susceptibility of bifidobacteria isolated from gastrointestinal tract of calves. Livest. Sci. 2006, 105, 253–259. [Google Scholar] [CrossRef]
- Kim, S.T.; Kang, Y.H.; Wang, Y.; Wu, J.; Park, Z.Y.; Rakwal, R.; Agrawal, G.K.; Lee, S.Y.; Kang, K.Y. Secretome analysis of differentially induced proteins in rice suspension-cultured cells triggered by rice blast fungus and elicitor. Proteomics 2009, 9, 1302–1313. [Google Scholar] [CrossRef]
- Salminen, S.; von Wright, A. (Eds.) Lactic Acid Bacteria Microbiology and Functional Aspects; Marcel Dekker: New York, NY, USA, 1998; pp. 359–367. [Google Scholar]
- Leslie, V.A.; Alarjani, K.M.; Malaisamy, A.; Balasubramanian, B. Bacteriocin producing microbes with bactericidal activity against multidrug resistant pathogens. J. Infect. Public Health 2021, 14, 1802–1809. [Google Scholar] [CrossRef]
- Banerjee, P.; Andres, O.E.; Anna, K.S.; Robert, P. ProTox-II: A webserver for the prediction of toxicity of chemicals. Nucleic Acids Res. 2018, 46, W257–W263. [Google Scholar] [CrossRef] [PubMed]
- Tolosa, J.; Barba, F.J.; Pallarés, N.; Ferrer, E. Mycotoxin Identification and In Silico Toxicity Assessment Prediction in Atlantic Salmon. Mar. Drugs 2020, 18, 629. [Google Scholar] [CrossRef] [PubMed]

| No. | Name of Antibiotics | P. pentosaceus |
|---|---|---|
| 1 | Ampicillin | R |
| 2 | Chloramphenicol | R |
| 3 | Streptomycin | R |
| 4 | Kanamycin | R |
| 5 | Nitrofurantoin | R |
| 6 | Gentamicin | R |
| 7 | Sulfamethoxazole/trimethoprim | R |
| 8 | Tetracycline | R |
| 9 | Cefoxitin | R |
| 10 | Cefuroxime | R |
| Parameters (Range) | Ochratoxin A |
|---|---|
| CNS (a –2 (inactive) to +2 (active) scale) | −2 |
| mol MW (130.0–725.0) | 403.818 |
| SASA (300.0–1000) | 643.884 |
| FOSA (0.0–750) | 177.286 |
| FISA (7.0–330) | 202.184 |
| PISA (0.0–450) | 203.448 |
| WPSA (0.0–175) | 60.966 |
| donorHB (0.0–6.0) | 1.25 |
| accptHB (2.0–20) | 6.5 |
| Qppolrz (13.0–70) | 38.323 |
| QPlogPC16 (4.0–18) | 12.555 |
| QplogPoct (8.0–35) | 19.694 |
| QplogPw (4.0–45) | 10.959 |
| QplogPo/w (–2.0–6.5) | 3.453 |
| QplogS (–6.5–0.5) | −4.931 |
| CIQPlogS (–6.5–0.5) | −5.647 |
| QPlogHERG (concern below –5) | −3.465 |
| QPPCaco (<25 poor; >500 great) | 38.85 |
| QplogBB (–3.0–1.2) | −1.611 |
| QPPMDCK (<25 poor; >500 great) | 40.38 |
| QplogKp (–8.0––1.0) | −3.953 |
| #Metab (1–8) | 4 |
| QplogKhsa (−1.5–1.5) | 0.087 |
| Human oral absorption (1–3) | 3 |
| Percent human oral absorption (above 80% was high; below 25% was poor) | 75.612 |
| Rule of five (maximum was 4) | 0 |
| Rule of three (maximum was 3) | 0 |
| Classification | Target | Prediction |
|---|---|---|
| Organ toxicity | Hepatotoxicity | Inactive |
| Toxicity end points | Carcinogenicity | Active |
| Toxicity end points | Immunotoxicity | Inactive |
| Toxicity end points | Mutagenicity | Inactive |
| Toxicity end points | Cytotoxicity | Active |
| Tox21-nuclear receptor signaling pathways | Aryl hydrocarbon receptor | Inactive |
| Tox21-nuclear receptor signaling pathways | Androgen receptor | Inactive |
| Tox21-nuclear receptor signaling pathways | Androgen receptor ligand-binding domain | Inactive |
| Tox21-nuclear receptor signaling pathways | Aromatase | Inactive |
| Tox21-nuclear receptor signaling pathways | Estrogen receptor alpha | Inactive |
| Tox21-nuclear receptor signaling pathways | Estrogen receptor ligand-binding domain | Inactive |
| Tox21-nuclear receptor signaling pathways | Peroxisome proliferator-activated receptor gamma | Inactive |
| Tox21-stress response pathways | Nuclear factor (erythroid-derived 2)-like 2/antioxidant-responsive element | Inactive |
| Tox21-stress response pathways | Heat shock factor response element | Inactive |
| Tox21-stress response pathways | Mitochondrial membrane potential | Inactive |
| Tox21-stress response pathways | Phosphoprotein (tumor suppressor) p53 | Inactive |
| Tox21-stress response pathways | ATPase family AAA domain-containing protein 5 | Inactive |
Publisher’s Note: MDPI stays neutral with regard to jurisdictional claims in published maps and institutional affiliations. |
© 2022 by the authors. Licensee MDPI, Basel, Switzerland. This article is an open access article distributed under the terms and conditions of the Creative Commons Attribution (CC BY) license (https://creativecommons.org/licenses/by/4.0/).
Share and Cite
Park, S.; Koo, J.; Kim, B.; Pushparaj, K.; Malaisamy, A.; Liu, W.-C.; Balasubramanian, B. Evaluation of the Safety and Ochratoxin A Degradation Capacity of Pediococcus pentosaceus as a Dietary Probiotic with Molecular Docking Approach and Pharmacokinetic Toxicity Assessment. Int. J. Mol. Sci. 2022, 23, 9062. https://doi.org/10.3390/ijms23169062
Park S, Koo J, Kim B, Pushparaj K, Malaisamy A, Liu W-C, Balasubramanian B. Evaluation of the Safety and Ochratoxin A Degradation Capacity of Pediococcus pentosaceus as a Dietary Probiotic with Molecular Docking Approach and Pharmacokinetic Toxicity Assessment. International Journal of Molecular Sciences. 2022; 23(16):9062. https://doi.org/10.3390/ijms23169062
Chicago/Turabian StylePark, Sungkwon, Jinsu Koo, Bosung Kim, Karthika Pushparaj, Arunkumar Malaisamy, Wen-Chao Liu, and Balamuralikrishnan Balasubramanian. 2022. "Evaluation of the Safety and Ochratoxin A Degradation Capacity of Pediococcus pentosaceus as a Dietary Probiotic with Molecular Docking Approach and Pharmacokinetic Toxicity Assessment" International Journal of Molecular Sciences 23, no. 16: 9062. https://doi.org/10.3390/ijms23169062
APA StylePark, S., Koo, J., Kim, B., Pushparaj, K., Malaisamy, A., Liu, W.-C., & Balasubramanian, B. (2022). Evaluation of the Safety and Ochratoxin A Degradation Capacity of Pediococcus pentosaceus as a Dietary Probiotic with Molecular Docking Approach and Pharmacokinetic Toxicity Assessment. International Journal of Molecular Sciences, 23(16), 9062. https://doi.org/10.3390/ijms23169062

